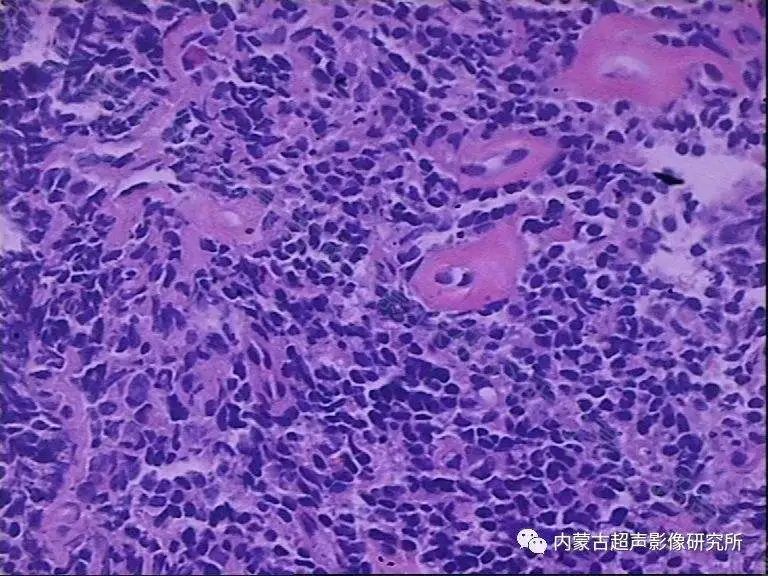
非霍奇金淋巴瘤的化疗方案有哪些？

“
由于非霍奇金淋巴瘤的亚型较多,且不同的分型预后不同,故选择的治疗方案不同,所以在这里我们将侵袭性不同的淋巴瘤的化疗方案分开介绍。


惰性淋巴瘤




弥漫性大B淋巴瘤




高度侵袭性淋巴瘤



非霍奇金淋巴瘤的
化疗方案有哪些
“
由于非霍奇金淋巴瘤的亚型较多,且不同的分型预后不同,故选择的治疗方案不同,所以在这里我们将侵袭性不同的淋巴瘤的化疗方案分开介绍。


惰性淋巴瘤

对于惰性淋巴瘤,可选用的化疗单药有烷化剂如苯丁酸氮芥、环磷酰胺等药物,有效后停药观察。烷化剂对于进展期的慢性淋巴细胞性白血病(CLL)有肯定的效果。缺点是缓解率低,不能延长患者的生存期。氟达拉滨为核苷类似物中的一种,于20世纪80年代开始用于临床,标准用法为25~30毫克/平方米/天,共用3-5天,静滴,每1月为一个疗程。用于初治慢性淋巴细胞白血病患者的完全缓解率(CR)为38%,部分缓解率(PR)为60%,疗效优于既往其他药物,但是使用2周期如未达PR者,提示预后不佳。氟达拉滨的主要不良反应为:骨髓抑制和免疫抑制,应用后易并发各种条件致病菌感染,部分患者可并发自身免疫性溶血性贫血(AIHA)、免疫性血小板减少性紫癜(ITP)等,老年人使用氟达拉滨应更为慎重。
治疗惰性淋巴瘤的联合用药方案有FC(氟达拉滨+环磷酰胺)、FMD(氟达拉滨+米托蒽醌+地塞米松)、FN(氟达拉滨+米托蒽醌)、CVP(环磷酰胺+长春新碱+泼尼松)或CHOP(环磷酰胺+阿霉素+长春新碱+泼尼松)方案等。对于CD20阳性者,NCCN指南推荐化疗联合利妥昔单抗治疗,结果显示,患者在治疗12个月后其部分缓解率(PR)为89%,利妥昔单抗联合化疗使用可明显提高患者的疗效。目前,层出不穷的新分子靶向药物为治疗惰性淋巴瘤提供了新的选择,相应的临床研究也在如火如茶地进行。



弥漫性大B淋巴瘤





对于弥漫性大B细胞淋巴瘤的初治患者而言,NCCN指南推荐的一线化疗方案为RCHOP21天方案(利妥昔单抗、环磷酰胺、阿霉素、长春新碱、强的松),以及RCHOP14天方案和R-EPOCH方案,以上方案由于都含有阿霉素,所以在化疗前应该对心脏功能进行评价,如果没有心功能不全的证据,可考虑使用以上方案,但由于一些心功能不全患者疾病具有隐匿性,故在使用以上方案时仍需密切观察阿霉素的用量和毒性。由于阿霉素累积量超过550毫克/平方米(体表面积),心肌病发生率将高达11%,因此阿霉素的累积量应在450~550毫克/平方米(体表面积)。而如果与长春新碱、博来霉素、环磷酰胺联用或纵隔区域接受过放疗,则阿霉素的累积量则应减至300~450毫克/平方米。而吡柔比星的急性心肌毒性低于阿霉素,建议的累积量为1000毫克/平方米。铂类药物比如卡铂、顺铂或奥沙利铂也有一定疗效,含铂类的方案DHAP(顺铂、阿糖胞苷、地塞米松)、DICE(顺铂、异环磷酰胺、依托泊苷、地塞米松)用于弥漫大B细胞淋巴瘤的二线治疗,除此之外,还有ESHAP(足叶乙甙、甲泼尼龙、高剂量阿糖胞苷和顺铂)方案、GDP(吉西他滨、顺铂、地塞米松)方案、ICE(异环磷酰胺、卡铂、依托泊苷)方案等联合利妥昔单抗也是其二线化疗方案。目前评价新的分子靶向药物联合 RCHOP 方案或替代利妥昔单抗治疗弥漫大B细胞淋巴瘤疗效的临床研究在世界范围内展开,我国各大肿瘤治疗中心也在致力于这方面的探索,试图为弥漫大B细胞淋巴瘤患者治疗寻找更有效的新的选择。



高度侵袭性淋巴瘤





高度侵袭性淋巴瘤包括伯基特淋巴瘤、前驱B/T淋巴母细胞性淋巴瘤及NK/T细胞淋巴瘤。CHOP方案对此型淋巴瘤效果欠佳,故对于此型淋巴瘤CHOP方案并不是其一线化疗方案。对于低危的伯基特淋巴瘤,指南推荐的联合化疗方案为CODOX-M IVAC交替方案及HyperCVAD方案(高剂量CHOP联合高剂量甲氨蝶呤及阿糖胞苷),同时联合利妥昔单抗。淋巴母细胞性淋巴瘤患者的治疗则推荐选用ALL方案,如HyperCVAD方案、BFM90方案,CALGB方案,阿糖胞苷联合大剂量米托蒽醌等。对于T细胞淋巴瘤,各种方案效果欠佳,推荐使用强烈化疗,如CHOP、EPOCH、HyperCVAD/ MTX-Ara-C方案,二线治疗方案包括有DHAP、ESHAP、ICE、 MINE(异环磷酰胺、米托蒽醌、依托泊苷)等方案。二线治疗中也可选择部分姑息性治疗方案如GDP等。在以上化疗方案使用过程中,应注意水化、碱化,防止肾衰竭的发生。


扫码打开当前页
之前
